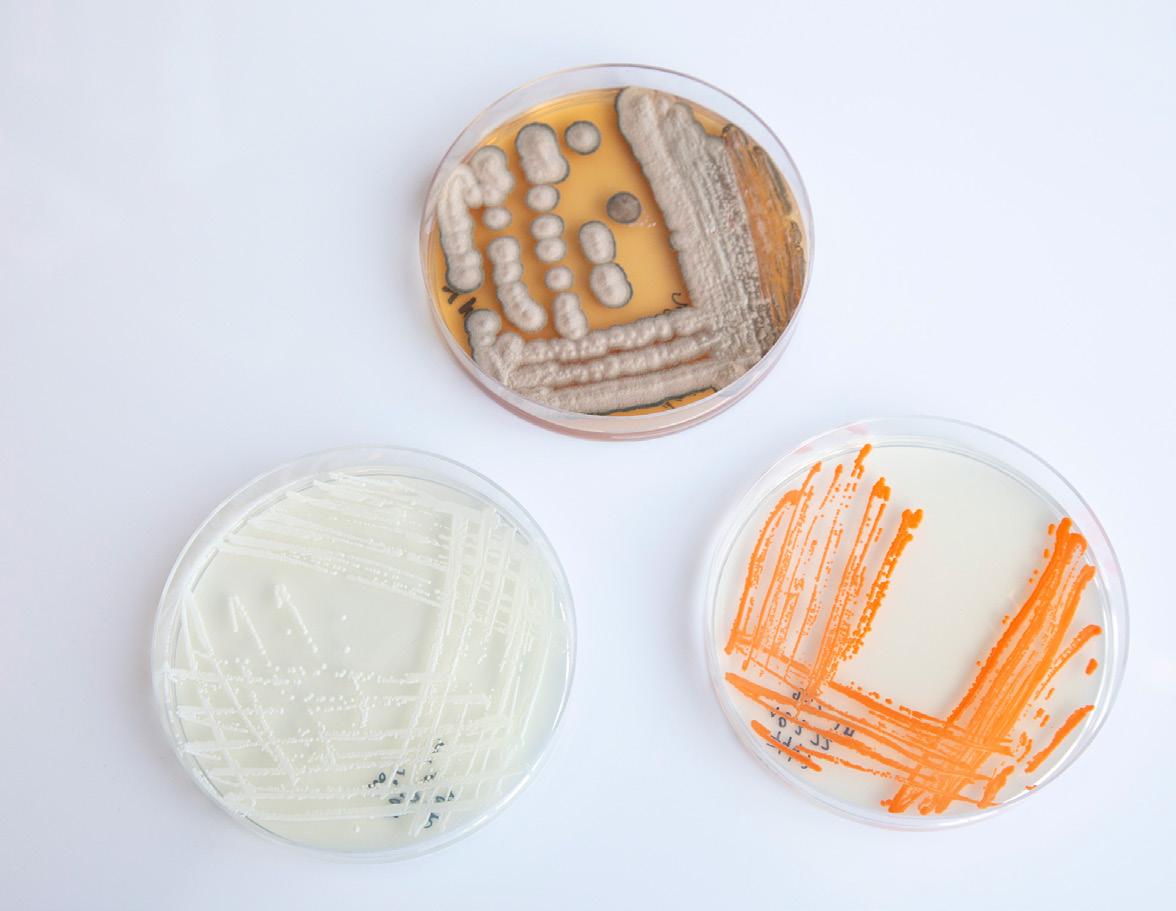
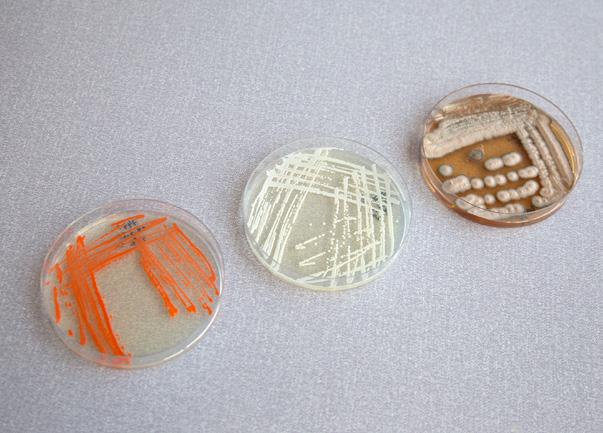
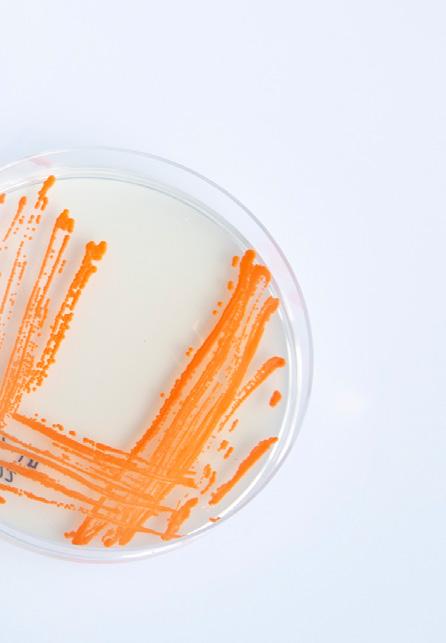

EXTRUDER AND EXPANDER TECHNOLOGY YOU CAN TRUST
Extruder AL300
Almex offers a wide range of single screw extruders and expanders which are used for different applications.

The robust and simple design of the Almex machines guarantees years of economical and trouble free production.
Scan the QR-Code for more information www.almex.nl
www.almex.nl



据估计,水产养殖业每年因疾病和水质相关 问题而损失720亿美元。虾农也通常因病原体 爆发而损失50%、75%,甚至100%的虾养殖 量。 这不仅彻底摧毁了农民的生计,还摧毁了数 百人,甚至数千人的蛋白质安全来源。当一个 农民因疾病而失去他的水产养殖量时,这不仅 是农民的损失,也是人类的损失。 随着世界人口的增长,水产养殖满足我们蛋 白质需求的压力也在增加,并且疫情造成了全 球供应链的中断,从而增大了这种压力。 再加上疾病的爆发,这三个问题在印度等地 引发了警报,那里的CP主任呼吁迫切需要创 新。 疾病的发生:可预防的或不可控制的 一旦疾病发生,这对人类来说是沮丧的和毁 灭性的(更不用说昂贵的费用了)。通常情况 下,疾病似乎毫无征兆地突然出现。就像病原 体爆发一样,一旦你看到病变或者白斑,预防 问题为时已晚。我们必须转向防御策略,尽可 能的减少损失和尽可能的挽救。 但病原体的爆发并不是凭空发生的。病原体 是狡猾的机会主义者,它们总是以少量无害的 数量出现,埋伏在那里等待合适的条件,这 样它们就可以进入到增殖模式。这些“合适的 条件”包括氧饱和度下降、化学失衡、氨的积 累、亚硝酸盐或有机固体的溶解等。 尽管有多种因素可以引起病原体爆发,但总 会有一个必然事件的发生来保证病原体爆发: 对微生物群落的致命破坏。一旦微生物群进入 了所谓的非生态状态或不平衡状态,就会产 生一个空洞。正如那句古谚语所说:大自然讨 厌真空。 病原体治理 病原体无处不在,而且它们会一直存在。 Luminis Water Technologies的首席执行官 Rachelle Jensen说:“我们已经对从公海到未受 污染的珊瑚环礁到世界各地的水箱和池塘的数 百甚至数千个样本进行了测序,我们从未见过 一个样本是没有病原体的。” 经过两年的全球抗击疫情,各国政府和公众 终于得出结论,零冠状态是徒劳的。新冠病毒 会一直存在,现在我们必须弄清楚如何最好地 治理它。 by
精准养殖 利用第二代微生物组分析技术预 防疾病 鱼类养殖技术 44 | 2022年9月 - Fish Farming Technology
Luminis Water Technologies, Singapore
可以对水、肠道、病灶、生物膜进行采样,并通过环境DNA 试剂盒发现水中的寄生虫。一旦样本被送回Luminis测序实验 室,它们将通过Luminis专有数据库进行第二代测序和数据匹 配,该数据库将序列匹配到物种水平。

AquaGENius提供了七个关键领域的见解:微生物群失衡、 病原体、蓝藻、藻类、生物多样性、益生菌和生物过滤细 菌。 其他用途包括:筛选被隔离的水产动物中是否有寄生虫和

水产养殖中的病原体治理也可以用同样的方式来思考。病 原体会一直存在。我们必须学会如何有效地治理它们,使它 们的生长机会很少。 这个挑战是棘手的,因为在维持水健康时,好的和坏的力 量都是细菌。用抗生素处理水以对抗病原体,也会杀死对水 质和水生生物健康至关重要的有益细菌。虽然这些措施减少 了病原体的数量,但也杀死了它们最坚定的盟友。 Luminis在病原体治理方面提出了一种不同的方式:利用微 生物组分析的力量。 微生物群掌握着关键 在一滴水中,有数百万的微生物构成了所有水生环境(包括 水箱和池塘)的健康基础。这个微生物群落包括许多有益细 菌、一些有害细菌、藻类、酵母、硅藻、病毒、噬菌体等 等。就像人类肠道微生物群一样,这些无形的生命共同支撑 着水和水产动物的健康和福祉。 把微生物组想象成一个复杂的基质,在水产动物和病原体 之间形成了一层看不见的面纱。当这种基质被鼓励生长时, 它就会成为病原体生长之间的屏障,同时推动水质等基本服
,保持系统化学,最大限度地提高承载 能力,并监测微生物群中的致命故障,从而培养有利于有益 细菌生长的条件。至关重要的是,第二代微生物组分析可以 让操作人员发现系统中的不平 衡,并在为时过晚之前采取措 施恢复微生物组。 “在养殖中,池塘承载力比 技术或工艺更重要。池塘健 康占80%,养虾占20%,” Dr Sharma说。 这是一个敏锐的观察,因为 随着承载能力的增加,微生物 群致命崩溃的几率也会增加。 水的监控——X射线 “基于第二代测序、人工智 能和互联网新技术的使用是水 产养殖业的未来,” Dr. Giana Gomes说。 第二代测序和分析提供的不 仅仅是已知或未知的病原体 ID。通过利用微生物组分析的 力量,鱼和虾养殖户可以利用 处于失衡和全面疾病事件之间 的关键机会窗口。 最重要的好处可能是能够做出有针对性的决策,从而降低 经营费用,提高产量。 第二代健康快照 分析不仅可以在拯救水产动物免受疾病爆发的影响方面提 供关键的机会窗口,而且Luminis Water Technologies还提供 了前所未有的”健康快照” 。 AquaGENius微生物群现场采样试剂盒简单易用。操作人员
务,并改善水产动物的生长和食欲。 一旦这种微生物基质被破坏或消灭,病原体就会得到一张“ 自由”的卡片,它们会毫毫不犹豫地利用新的条件。 疾病预防的秘密是,通过适当播种益生菌、NOBs和AOBs( 亚硝酸盐和氨氧化菌)
害虫(如水蛭),跟踪饲料和益生菌效率,确定导致水质下降 的病原体,以及验证一种处理方法是否真的杀死了所有病原 体,还是只是减少了数量。 了解样本中的“谁”以及他们在做什么,可以帮助我们做出 更好、更精确、更有针对性的决策,最终实现更明智、更可 持续的水资源利用。 Luminis Water Technologies致力于提供数据驱动和可操作的 解决方案,帮助解决当今水管理和水产养殖业中一些最紧迫 的问题。 新加坡科技公司Luminis Water Technologies试图通过提供一 系列第二代微生物组分析解决方案,将水产养殖业的效率提 升到一个新的水平。 中国海洋大学 张彦娇博士 翻译 About Luminis Water Technologies The Singapore-based tech firm, Luminis Water Technologies, seeks to take the aquaculture industry to a new level of efficiency by offering a range of Next Gen microbiome analytical solutions. 鱼类养殖技术 45 | 2022年9月 - Fish Farming Technology







科技展示 本月的创新 2022年9月 在本月的产品展示中,我们讨论了水产养殖中的水质问 题,这在RAS设施中尤为重要,包括排水废物收集系统、 智能监测系统和紫外线消毒系统,所有这些都可以改善养 鱼业的水质。 如果您希望您的产品或服务出现在International Aquafeed and Fish Farming Technology杂志的未来 版本中,请联系我们: editorial@perendale.co.uk Learn more – Learn onsite Enroll in the 12-week Course AKVA集团的SmartEye模块 SmartEye Modular是一款先进的双馈的检查摄像头,可为操作员提供高清质 量的图像。作为一个光敏相机,并且能360°观察圈养鱼的围栏,它运行定制 的固件,以优化水下环境中的操作。这样,即使在深色的围栏中操作,它也 能提供高质量的水下视频图像。 SmartEye模块化摄像头系统是完全可调配,以此来满足操作者当前和未来的 需求。它具有易于使用的软件和强 大的无线视频传输。 相机配有内置的深度和温度传感 器,可与其中一个绞车系统结合。 其他值得注意的特点是其有坚固的 外壳设计、自动调节的色彩平衡和 一个全新的照明组件,这种照明组 件即使是在最黑暗和最深的环境也 可以观察到周围环境。 www.akvagroup.com
pH传感器,用于监测海洋和水 路。使用ANB的专利技术,传感器无 需校准,机械很坚固,可以潮湿或干 燥储存,需要最少的用户干预。 如今的海洋 pH 传感器使用光学传感 器,这些传感器使用各种大型、昂贵 或需要每年重新校准和校正深度和盐 度的技术。ANB的传感器避免了这 一切。 目前,公司拥有OC系列和AQ系列, 后者专为水产养殖和淡水监测而设 计。AQ系列的特点包括易于养护、易 于存储、快速简单的自动启动测量和 板载温度测量。 其他特性包括2 –10的pH检测范围、-5 –40°C的工作温度和110mA的功耗。 www.anbsensors.com Faivre Helios 40鱼类分级器 Faivre的Helios 40是以经济实惠的价格将高精度和高速的分级系统相结合, 是Faivre专门生产和设计来满足养鱼户的要求的分级器。 除了对鳟鱼和鲑鱼进行从10克到 1
Helios 40
200
道。 它们的主要优点包括具有执行Sps 技术的平地机配件,用于高速分 级而不会造成伤害,由优质AISI 304L或316L不锈钢(海水)制 成,由于其具备升降千斤顶和配 备调节门的锻炼浇水系统使得它很易于调节。 www.faivre.fr aqfeed.info/e/1601 FISH FARMING TECHNOLOGY fishfarmingtechnology.net Check out our website dedicated to fish farming technology
ANB Sensors 的 AQ 系列 ANB Sensors提供一系列不同尺寸和规格的
公斤不等的分级能力,
还有三个分拣能力为每小时
克的25,000条鱼的分拣通




科技展示 www.onlinemillingschool.com Kaeser 的小型压缩机 Kaeser Compressor的小型压缩机用途广泛、可靠且易于运输,占用的装载 空间极小,并配备了高品质电机和抗冲击PE外壳,可以应对任何情况。 小型压缩机可处理7至15bar的最大压力,15bar版本非常适合非开挖铺设光 缆。 它的优势包括可以快速部署到任何位置,因为小型压缩机重约 200 公斤因此 很易于装载,可以提供对用户很友好的控制系统并且操作直观,以及可提供 最佳噪音和冲击保护的旋转烧结PE外壳。 该系列还配备了可承受高达15bar压力的电动机。 使用环保型号的好处是它 们在需要安静和无排气条件的环 境中可以良好运行。 www.kaeser.co aqfeed.info/e/1602 RiaWatech 的 Ria Flow Guide 三通阀 基于RiaWatech超过35年的水产养殖 经验,推出了一款新产品,即 Ria Flow Guide 三通阀。易于安装和操作,芯部弯 曲半径旨在减少对鱼的伤害,HDPE唇部针 对RAS中的压力优化了厚度。 它包括一个机械位置指示器,因此操作员能 够看到核心的位置并避免错位,同时还具有 不锈钢精密凸轮来确保正确读数。 该阀门采用圆形内部边缘设计,旨在减少对 鱼类的伤害,从而为养殖者带来更高的产量 和更高的盈利能力。它配备带吊眼的支架 和带固定板的支腿,确保快速轻松安装以 降低成本。 https://riawatech.dk International Aquafeed - 2022年9月 | 47
25.2

8.7 9.4 10.0
11.0 12.8
水产养殖案例研究 有机鲷鱼和虹鳟 鱼生产 ——测试豌豆蛋白和海藻作为 新蛋白来源的可行性 由于市场需求有限和生产技术困难,有机有鳍鱼的产量没 有增加。利益相关者发现了一些与动物福利方面难以遵守欧 盟法规(EU 2018/848)相关的障碍。 这些障碍包括有机生产与传统生产的分离、有 机饲料的可用性和高成本、有机认证幼鱼的可用 性、寄生虫的管理以及使用比传统养殖低的鱼密 度进行有机养殖,这导致了较高的生产成本,但
增强有机产品的作用 欧盟委员会(2021)发布了一项行动计划,以 加快有机产品的发展。该计划旨在促进有机产品 的生产和消费,以便到2030年达到25%的有机农 业用地,并大幅增加有机水产养殖,如欧盟从农 场到餐厅和生物多样性战略所规定的那样。 该计划由23项行动组成,为该部门提供了正确 的工具,并加强了有机产品在应对气候变化和可 持续资源管理中的作用,为更健康和生物多样性 的生态系统做出贡献。 有机产品发展行动计划提出了围绕三项措施的行动: 1. 促进消费,同时保持消费者信任 Table 1: Formulation (% inclusion) and FM/FO ratio of the feeds used in the ongrowing of rainbow trout and gilthead seabream
0.03
-FM/FO 47.5/14.3 33.0/15.0 19.0/15.6 51.3/8.7 38.5/9.4 25.6/10.0 CS 根据EUMOFA(2022年),2020年欧盟有机水产 养殖总产量达到74032吨(占欧盟水产养殖总产值的 6.4%),其中贻贝是主要生产品种(41936吨),其 次是三文鱼(12870吨)、鳟鱼(4590吨)、鲤鱼 (3562吨)、牡蛎(3228吨)和欧洲鲈鱼/金头鲷 (2750吨)。 作者:Alicia Estévez(西班牙塔拉戈纳圣卡洛 斯德拉拉皮塔农业研究与技术研究所(IRTA)研 究员)&Phely Vasilaki(希腊Nea Artaki Evia Irida SA研发管理 48 | 2022年9月 - International Aquafeed
价格溢价无法弥补。
under organic conditions. Rainbow Trout Gilthead Sea Bream Ingredients (%) CTRL PEA 10% PEA 21.5% CTRL PEA 8.5% PEA 19% FM from timmings 47.5 33.0 19.0 51.3 38.5 25.6 Organic soybean meal 24.0 24.0 24.0 25.2 25.2
FO from trimmings 14.3 15.0 15.6
Organic wheat 13.7 12.1 12.4 14.4
Organic pea protein - 10.0 21.5 - 8.5 19.0 Organic yeast - 5.0 5.0 - 5.0 5.0 Seaweed - - - - 2.0 2.0 Organic premix (vit + min) 0.25 0.25 0.25 0.25 0.25 0.25 Choline 50% 0.15 0.15 0.15 0.15 0.15 0.15 Natural antioxidant 0.03 0.03 0.03 0.03
0.03 Monosodium phosphate - 0.7 1.95 -



























































































2. 增加产量 3. 进一步提高该行业的可持续性 因此,为了提高有机海鱼的产量,需要新的、更便宜的蛋 白质来源,以降低生产成本,同时不降低鱼的生长和食物利 用率,并确保在生长阶段结束时获得高质量的产品。 减少鱼粉量 IRTA和Irida开展了一项试验,作为新技术水产项目(H2020, 项目862658)的一部分,研究使用经认证的有机豌豆蛋白和 海藻作为有机虹鳟和鲷鱼生长的新成分。Irida使用两种不同 的豌豆蛋白包合水平配制和制备饲料,同时减少所含鱼粉的 量(表1)。 将实验饲料喂给虹鳟(60g)和金头鲷(145g)幼鱼, 每天两次,持续60天。试验期间,鱼在EU2018/848规 定的条件下饲养,即开放式系统,无氧气添加,密度低 (最大25Kg/m3)。 试验结束时,对所有鱼称重,以计算相对生长率 (RGR,%)和特定生长率(SGR)。每缸处死5条鱼,解 剖肝脏和内脏,计算内脏(VSI)和肝体(HSI)指数。背部 肌肉和肝脏样品用于生化分析:蛋白质和脂质含量以及脂肪 酸分布。 在这两个试验中,喂食对照饲料的鱼在SGR和RGR方面都 表现出最高的生长率。在虹鳟鱼中,与对照组相比,饲喂低 Table 2: Growth indices (SGR: Specific growth rate, RGR: Relative growth rate) Feed conversion rate (FCR), sometic indices (HSI: Hepatosomatic, VSI: Viscerosomatic) and fillet yield (%) of gilthead seabream fed the experimental diets including organic pea protein at 8.5 and 19% inclusion. Different letters indicate significant differences. Sea Bream SGR RGR FCR HSI VSI Fillet yield Av SD Av SD Av SD Av SD Av SD Av SD CTRL A 0,68 0,05 a 53,08 4,34 a 2,58 0,26 2,13 1,26 8,44 4,13 29,63 12,96 PEA 8.5% B 0,62 0,05 b 47,45 4,68 b 2,79 0,34 2,74 1,25 10,75
PEA 19% C 0,59 0,00 b
0,42 b 3,05 0,82
ANOVA P<0.001 <0.001
CS International Aquafeed - 2022年9月 | 49
5,22 32,90 15,64
45,35
2,51 1,50 10,74 5,40 32,67 15,60
0.19 0.623 0.532 0.873
0.32 13.07 2.26
25.89
豌豆蛋白饲料的鱼显示出无统计学差异的生长速度。 在鲷鱼(表2)的情况下,所有指标(体细胞和饲料转化 率)在饲料之间没有差异,而虹鳟鱼(表3)的转化率最 好,饲料中含有10%的有机豌豆蛋白,而饲料中含有21.5% 的豌豆蛋白的鱼表现出最高的VSI,表明内脏周围脂肪积累 更高。 当喂食豌豆蛋白含量最高的鱼时,这两种鱼的鱼片成分 (表4)显示出较高的蛋白质含量,而喂食豌豆蛋白含量最 高鱼的鱼肉中脂质含量也最低。
虹鳟鱼中的脂肪酸成分表明,饲料中豌豆蛋白含量低 (10%)可生产出鱼片和肝脏中与对照组成分相似的鱼。 就鲷鱼而言,用最低豌豆蛋白(8.5%)喂养的鱼鱼片中二 十二碳六烯酸(DHA)和总ω-3脂肪酸含量最高,而肝脏中 ω-6和单不饱和脂肪酸的含量最高,反映了饲料的脂肪酸组 成。

类似的增长率
获得的生长速度相似。鳟鱼和鲷鱼这两种鱼类 的饲料转化率也与对照组相似,特别是使用较 低的豌豆蛋白含量。 就蛋白质和脂肪酸含量而言,最终产品质量也 非常高且健康,为市场上的鱼提供了附加值。 减少鱼肉中的杂质含量也有助于降低高磷含 量,降低饲料成本。 进一步阅读 EUMOFA2022.欧盟的有机水产养殖。现状、 驱动因素、障碍、增长潜力,48页。WWW. EUMOFA.EU 欧洲委员会。2021。新的行动计划将促进欧 洲的有机农业和水产养殖。海事和渔业总局。 https://oceans-and-fisheries.ec.europa.eu/news/ new-action-plan-will-boost-organic-agricultureand-aquaculture-europe-2021-03-25
华中农业大学
译 Table 3: Growth indices (SGR: Specific growth rate, RGR: Relative growth rate) Feed conversion rate (FCR), sometic indices (HSI: Hepatosomatic, VSI: Viscerosomatic) and fillet yield (%) of rainbow trout fed the experimental diets including organic pea protein at 10 and
CS 50 | 2022年9月 - International Aquafeed
总之,单独或与海藻蛋白一起加入经认证的有机豌豆蛋白 产生的生长速度与使用商业有机饲料作为对照
en 如有需要,可提供所有参考资料。
王庆超博士
21.5 % inclusion. Different letters indicate significant differences. Rainbow trout SGR RGR FCR HSI VSI Fillet yield Av SD Av SD Av SD Av SD Av SD Av SD CTRL A 1.81 0.115 a 68.48 2.362 a 1.31 0.12 b 1.37 0.18 12.49 1.65 b 25.29 1.77 PEA 10% B 1.75 0.025 a 67.34 0.526 a 1.18 0.03 c 1.43
b
1.89 PEA 21.5% C 1.62 0.071 b 64.57 1.637 b 1.98 0.14 a 1.65 0.32 16.33 1.57 a 25.07 2.17 ANOVA P<0.001 <0.001 <0.001 0.107 <0.001 0.659 Table 4: Protein and lipid content (% dry weight) of rainbow trout and gilthead seabream fillet at the end of the feeding trial. RAINBOW TROUT FILLET GILTHEAD SEABREAM FILLET CONTROL 10% ORGANIC PEA 21.5% ORGANIC PEA CONTROL 8.5% ORGANIC PEA 19% ORGANIC PEA Av SD Av SD Av SD Av SD Av SD Av SD Water (% ) 70,92 0,32 71,99 0,07 73,18 0,34 71,38 0,35 71,90 0,29 72,45 0,18 Protein (%) 60,25 1,04 59,89 0,89 66,71 3,89 59,17 2,22 62,97 3,93 70,26 1,78 Lipids (%) 12,81 0,25 12,88 0,54 10,87 0,48 12,01 0,17 10,61 0,07 8,37 0,11
The Packaging Group GmbH Gerberstraße 50 · 51789 Lindlar, Germany · www.the-packaging-group.com






















































YOU CAN THINK IT
CAN PACK IT
IF
WE
Watch our sustainable packaging solutions at: www.the-packaging-group.com/videoportal
Status updates for industry events amidst global effects of COVID-19

2022
2022 September
1-3
Taiwan SMART Agriweek 2022 Taipei, Taiwan www.taiwanagriweek.com
6
Aquaculture Innovation Forum London, UK aquacultureinnovationforum.com
4-6
Fish International 2022 Bremen, Germany https://fishinternational.de




7-8
Seagriculture USA 2022 Portland, Maine, USA https://seagriculture-usa.com



13-15
SPACE 2022 Rennes, France http://uk.space.fr


22-23
Aquaculture New Zealand Conference 2022 Nelson, New Zealand www.aquaculture.org.nz
New Zealand’s Aquacultural Association, Aquaculture New Zealand, is organising their 2022 Conference from 5-6 October at Rutherford Hotel in Nelson, New Zealand. Focusing on innovative technology and targeted research to help build resilience, improve performance, advance infrastructure, and strengthen productivity within the industry, The New Zealand Aquaculture Conference is widely celebrated as New Zealand's best primary sector conference.

With Covid-19 causing the two previous conferences to be cancelled, the colloquium would be bringing the industry and stakeholders together for a two-day in-person gathering full of inspirational speakers, thought-provoking discussions, unparalleled networking opportunities. Along with this the Aquaculture New Zealand Conference also aims to have more discussions on biosecurity practices, developing a flourishing workforce and inviting Māori tribal investment.
27-30
Aquaculture Europe 2022 Rimini, Italy www.aquaeas.org

2022 October 12-14
Vietstock 2022
Ho Chi Minh City, Vietnam www.vietstock.org
2022 November
3-5
Future Fish Eurasia Gaziemir – Turkey https://eurasiafairs.com
The 10th International Fair for Fish Imports/Exports, Processing, Aquaculture and Fisheries Future Fish Eurasia, has been organised for November 3-5, 2022, at the Fair Izmir Centre, Turkey.

At this event organised by Eurasia Trade Fairs, over 200 local and international brands of the industry will display their latest products and services in seafood products, aquaculture, fish processing and fishing equipment.
As Turkey's only fair for the industry and the leading event of the region, Future Fish Eurasia is the gateway to new/emerging markets. The dynamic structure of Turkish aquaculture and Future Fish Eurasia form a perfect platform for those in the fish business.
This show will provide an opportunity to introduce aquaculture and/or processing technology to Turkey and its neighbouring countries, and also buy high quality seafood products or sell alternative seafood.

9-11
AFIA Equipment Manufacturers Conference 2022 St. Petersburg, Florida, USA www.afia.org

9-11
Ildex Indonesia 2022 Jakarta, Indonesia www.ildex-indonesia.com


15-18
EuroTier 2022 Hannover, Germany www.eurotier.com
29-2
World Aquaculture Singapore 2022 Singapore www.was.org

2022 December 13-15
AlgaEurope 2022 Rome, Italy

https://algaeurope.org


Aquaculture America 2023 New Orleans, Louisiana, USA www.was.org 2023 March 8-10
VIV Asia 2023 Nonthaburi, Thailand www.vivasia.nl 2023 May 29-1

World Aquaculture 2023 Darwin, Australia www.was.org 2023 June 8-10
VIV Turkey Istanbul, Turkey www.vivturkey.com
行业盛会
2023 2023 February 23-26
☑ See The International Aquafeed team
this
52 | 2022年9月 - International Aquafeed
at
event




































































Nov. 29 - Dec. 2, 2022 Conference Sponsors Temasek Polytechnic, Nanyang Technological University National University of Singapore, James Cook University Republic Polytechnic 3rd International Symposium on Perch and Bass Associate Sponsors Aquaculture Engineering Society International Association of Aquaculture Economics & Management WorldFish World Aquaculture Singapore 2022 WA2020 Partner @WASingapore WASAPC @WASAPC The Annual International Conference & Exposition of World Aquaculture Society Asian Pacific Aquaculture 2022 – Annual Meeting of Asian Pacific Chapter, WAS Hosted by Singapore Food Agency WAS Premier Sponsors Singapore EXPO Convention & Exhibition Centre and MAX Atria Sustainable Aquaculture for Two Oceans HOTEL RIU PLAZA Panama City, Panama April 18-21, 2023 The annual meeting of LATINAMER CAN&CARIBBEA N RETPAHC Get our meeting mobile app Hosted by Latin American & Caribbean Chapter/World Aquaculture Society -WAS LACC@laccWas LACC World Aquaculture Society Premier sponsors @LACC_WAS Conference sponsor Latin American & Caribbean Aquaculture 2023 February 23-26, 2023 New Orleans Marriott New Orleans, Louisiana Aquaculture America Associate Sponsors World Aquatic Veterinary Medical Association Aquacultural Engineering Society Aquaculture Association of Canada Global Seafood Alliance International Association of Aquaculture Economics and Management Latin American Chapter WAS • US Trout Farmers Association SPONSORED BY: Food For The Future 2023 WAS Premier Sponsors For details: aquacultureassociation.ca | was.org | naia.ca AUG. 15 - 18, 2022 ST. JOHN’S CONVENTION CENTRE ST. JOHN’S NEWFOUNDLAND AND LABRADOR, CANADA For More Information Contact: Conference Manager | P.O. Box 2302 | Valley Center, CA 92082 USA Tel: +1.760.751.5005 | Fax: +1.760.751.5003 | Email: worldaqua@aol.com | www.was.org Trade Show Contact: mario@marevent.com WA 4 show AD 26 x 33.6 cm.indd 1 4/5/22 12:56 PM

2022年8月,世界上最大的渔业技术展览会之一Nor Fishing 2022在挪威特隆赫姆举行。这是自2018年以来首次举办实体 展览。2020年,主办方Nor Fishing Foundation选择举办一场 纯粹的数字活动,取得了巨大成功。在这之后,基金会董事 会决定转向一个新的“混合”平台,该平台除了传统的实体展 览之外,最终将提供一个数字活动。 为了确定这种新形式是否被组织者视为成功,《国际水产 饲料》杂志最近采访了基金会首席执行官克里斯蒂安·迪格 雷。 决定搬到一个混合展览而不仅仅是一个实体展览的考 虑因素是什么? 我们在2020年举办数字活动的原因是,我们觉得我们真正 在场很重要。我们有点担心自己会被遗忘。一段时间以来, 我们一直在讨论增加数字服务,但新冠肺炎疫情迫使我们加 快了计划。 事实上,我们只有三个月的时间来开发新平台,但在真正 优秀的专业人员的帮助下,我们设法及时准备好了。 除了传统的展览,您认为拥有数字服务的优势是什 么? 数字服务使我们能够接触到因各种原因无法来特隆赫姆参 加体育活动的人。甚至在2021,当我们举办另一个展览Aqua Nor时,许多人因为新冠肺炎大流行而出现问题。 2021,只有北欧公民被允许进入挪威,在阿卡诺尔展览 上,我们通常有70-75个国家。但同样重要的是,数字版保留 在网络上,在实际展览结束后整整一年都可以访问。 混合平台具体由什么组成? 我们的概念相当复杂,不仅包括数字展览,每个参展商都 有一个可以访问的“主页”。参观者还可以预订与参展商的一 对一会议,他们可以跟踪直播,在展会期间,每天直播5个 小时。 此外,我们使用各种社交媒体,如 Facebook、Instagram、LinkedIn、YouTube等,来接触我们的 受众。 这么复杂的展演一定需要很多人来操作? 我们只有两名全职员工,但我们有许多兼职助手,我们使 用专业的电视制作人进行直播,并提供许多其他临时技术和 新闻帮助。 你还有一个相当大的专业课程,有很多演讲等等。 是的,这是我们在特隆赫姆的两个科学机构的帮助下建立 起来的:SINTEF和挪威技术大学(NTNU)。 该计划以全天会议开始,会议在实际展览开幕前一天举 行,包括展览期间举行的一系列研讨会。我们还就当前议题 进行了一些辩论。这些辩论可以有来自世界各地的参与者, 他们通过互联网联系在一起。 然后,我不应该忘记提到学生节,这是在展览的最后一天举 行的。我们举办了一个特别项目,邀请来自各地的学生参观 参展公司。这已经很流行了。今年我们有730名学生注册。 今年的展览怎么样?你满意吗? 的确如此。尽管我们的实际观众比往年少(约15000人), 一个新的“混合”平台 也不钓鱼 54 | 2022年9月 - International Aquafeed




但参展商对观众的质量表示非常满意。当然,我们和往常一 样,在整个展览期间都能享受到最美妙的夏季天气。 实际的展厅由几个大厅组成,不是吗? 是的,有五个不同的展厅,我们尝试将特定领域的参展商 聚集在一起。例如,在一个大厅里,我们专注于电子产品, 这是一个不断发展的领域。在另一个国家,我们有造船厂等 等。然后我们有户外展商,包括特隆赫姆港的水上展商,距 离展览馆只有十分钟的步行路程。 I understand Nor-Fishing is one of the oldest fisheries technology exhibitions around. How long have you been operating? 嗯,它始于1960年,当时举办了第一次展览。第二次是在1965 年。自1972年以来,我们每隔一年举办一次Nor Fishing展览, 自1979年以来,它与我们的另一个展览Aqua Nor交替举办,该 展览专注于水产养殖技术。你会相信吗,今年我们有一位参展 商,他自1965年以来参加了每一场展会,这是我们举办的第二 场展会。当时,他13岁,陪伴着父亲,父亲是一名参展商。 您提到数字版将在一整年内可用。这是否意味着我现在可以 通过互联网访问它? 对我们在演出结束两周后向公众免费开放,并在2023年7月 31日前一直在互联网上播放。 您可以在我们的网站上找到: https://aqfeed.info/e/1596
Kari Steinsbø and Kristian Digre, Nor-Fishing.
行业盛会 International Aquafeed - 2022年9月 | 55
Kristian Digre (centre) and colleagues receive an award for contributions to the cultural fabric of Trondheim.
核心成分的使用进行了乐观的重新评估。 Eckel’s Viktor Eckel博士对他们的产品留下了非常深刻的印 象,就植物性饲料添加剂如何真正解决水生动物生产健康问 题而言,他们关注的是罗非鱼和虾在病原挑战测试后的存活 率,这些测试数据来自功能性免疫相关调节剂的实验工作。 同样,Octavio Castro博士对Phileo如何推进病原体与肠道相 互作用的缓解,以及他们的酵母产品如何解决这一平衡,从 而在实践中显著提高鱼虾的健康进行了内容丰富的演讲。

我在泰国曼谷IMPACT展览和贸易中心举行的Victam亚洲健 康与营养会场为您报道。 此次会议于2022年9月7日至9日举行,吸引了亚洲和全球动 物饲料行业的大量利益相关者。这次会议是饲料生产技术的 真正展示,如铣削和磨削设备,以及各种类型的造粒机械。 展出的是一系列产品 从简单的蒸汽调节造粒机,到先进 的单螺杆和双螺杆挤压设备,用于生产动物饲料、颗粒宠物
和稳定剂的喷涂和真空镀膜。其中包括添加敏感饲料补充剂 和添加剂(如维生素、色素和药物)的追肥饲料解决方案。 考虑到最佳条件和能源成本,干燥技术也非常重要。 创建循环生物经济 当然,我特别关注的是水产养殖部门,我们在9月6日举办 了亚洲水产活动,这是在VIV下单独举办的一次特别会议, 概述了鱼类和甲壳动物营养研究与发展的一些关键领域。 我很高兴成为主题演讲人,并与我们Perendale Publishing有 限公司的Roger Gilbert和Tuti Tan共同主持。我就创建循环生 物经济的最新愿景发表了讲话,并提供了我自己研究从生物 乙醇生产中提取的发酵小麦蛋白的例子;来自生物燃料或饮 料行业,如啤酒厂和饮用酒精公司。 玉米或小麦发酵蛋白在鱼和虾饲料中的利用及其功能和营 养特性的开发具有很大的潜力。其他同事谈到了泰国的水产 饲料潜力,与亚洲当地的一系列物种有关,如鲇鱼、蛇头 鱼、罗非鱼、石斑鱼和鲈鱼。罗非鱼是这个地区非常重要的 鱼类。 来自越南的Loc Tran博士描述了健康管理和营养方法,以 获得更富有活力的虾。这也是我在第二次演讲中提到的一个 主题。Noratat Prachom博士通过泰国的案例研究,谈到了可 持续水产养殖和水产饲料制造的生物循环绿色经济模式的可 能性。 我们很荣幸地邀请到来自AIT(亚洲理工学院)的Ram C Bhujel博士,他在泰国水产养殖领域拥有丰富的经验,并为 我们提供了非常积极的未来展望。代表USSEC水产养殖技术 项目承包商的
有趣的互动 在贸易展上,水产养殖方面的内容非常引人注目。我对荷 兰主办的昆虫工程师和昆虫学校的展台非常感兴趣,该学校 为他们的幼虫粉提供黑蝇生产培训。 这是我们从各种商业企业中多次报道的事情。我还被一家 名为Celtic Minerals的新公司所吸引,这家公司起源于爱尔 兰,是一家从海底采集降解海藻生物的副产品的公司。 由此产生的富含钙的沉积物还具有一系列微量元素,这 些微量元素可以为饲养中的鱼和虾提供高度生物可利用的 营养来源,或者通过增加生产池塘中的水环境并支持营养 食物网的初级和次级生长。规模更大、更熟悉的公司,如 DSM、Evonik和Trouw也出席了会议,并提供了有关其特定 和众所周知的动物饲料添加剂和补充剂的信息。 我还能够在加来海峡隧道尽头附近赶上来自法国的同 事。Soprapeche曾经是一家专注于海洋成分的专业公司,如 高级鱼粉和水解产品。现在,他们已经扩大了产品组合,为 利润丰厚的宠物食品市场提供了各种植物和其他陆生专业的 高质量动物副产品。 它们确实是水解蛋白浓缩物的前沿,已知其在鱼虾水产 共同举办的活动展示了可持续水产养殖和水产饲料制造 解决方案的未来 作者:Simon J Davies教授,国际水产饲料杂志主编,英国 健康与营养,2022亚洲 VICTAM 行业盛会 56 | 2022年9月 - International Aquafeed
食品,当然还有水产饲料。 特别是那些促进新型挤压后调节工艺的代表,如乳液、油
Lukas Manomaitis对豆粕作为水产饲料的资源




养殖中具有巨大潜力的功能特性。此外,我还与比利时 Impextraco公司进行了富有成效的讨论,该公司专门研究农 场动物饮食中的矿物质、色素、氨基酸和抗氧化剂,目前也 在鱼和虾上测试他们的产品。 另一个非常有趣的互动是我与总部位于意大利的Eurofeed Technologies就其饲料添加剂产品组合进行的长时间交谈。 我对几家总部位于亚洲的公司的存在印象深刻,这些公司 正在开发健康产品,这些产品以有机补充剂、免疫兴奋剂和 各种定制的益生元和益生菌产品的形式提供良好的营养。这 是我自己研究重点的一个活跃领域,我发现他们讨论此类产 品潜力的开放性让我耳目一新,也让我有机会支持他们的愿 景。 铣削和挤压设备的领先制造商 在会议期间,我们与来自中国的Famsun高级职员举行了一 次会议,讨论了他们作为铣削和挤压设备的主要制造商的议 程,这些设备涉及谷物和加工的各个方面,动物饲料技术, 当然,与水产饲料生产具有很强的相关性。 技术和世界商业的挑战构成了讨论的核心,对未来有许多 积极的思考。会场提供了许多附带会议,并为关键的成功案 例颁发了创新奖。 AFTAN动物饲料与营养奖和GRAPAS奖备受垂涎,突出企 业和创新。作为一名VIP与会者,我很高兴参加晚间接待活 动,并有机会在更轻松的环境中结识他人。 自助餐非常棒,有当地的泰国和亚洲菜肴,还有精选的葡 萄酒和啤酒。 一个愉快和温暖的体验 回来参加面对面会议确实是一次很好的经历,这一切都是 值得的。毫无疑问,今年和2023年将有更多人参加类似会 议。 天气总体上是宜人和温暖的,但在欧洲的一场大旱之后, 我很高兴在一个晚上经历了热带雷暴和大雨 看到一条被洪 水淹没的道路对我来说很奇怪。 作为一名英国公民,在访问即将结束时,我听到了伊丽莎 白二世女王陛下逝世的悲痛消息,收到了许多人的吊唁。 我想借此机会感谢所有花时间参加这次活动的人,感谢他 们的友好和支持。 大连海洋大学 左然涛博士 翻译 行业盛会 See the photo album from VICTAM Asia at: aqfeed.info/e/1643 International Aquafeed - 2022年9月 | 57









NEW! SÃO PAULO BRAZIL LATIN AMERICA’S LARGEST DEDICATED EVENT FOR THE ANIMAL FEED AND GRAIN PROCESSING INDUSTRIES WHY EXHIBIT? �Brazil is the third producer of animal feed in the world with 1.600 feed mills and a production of 90 million tons per year and 4th largest grain producer in the world �Meet (potential) customers from all over Latin America �High quality visitor profile within your industry �Meet delegates from various trade missions from surrounding countries �Elaborate conference program and the possibility to present your own technical seminar �The platform to launch your innovation for maximum exposure �Victam LatAm will be a bi-annual event so the next opportunity to exhibit will only be in 2025 WHEN AND WHERE: �October 3 - 5, 2023 �Expo Center Norte, Red pavilion, São Paulo, Brazil. CO-LOCATION VICTAM LatAm is co-located with GRAPAS LatAm, the event for the grain milling and processing industries and with GEAPS, the biggest and best show in the grain industry! BRAZIL São Paulo NEW! in 2023 • Animal Feed • Agua Feed • Pet food • Poultry feed • Flour milling • Grain processing, handling & storage Since 1965 – Victam International Since 1993 – Victam Asia Since 2021 – Victam EMEA MORE INFORMATION envelope NICKMOUTHAAN@VICTAM.COM � +31 6 2126 4398 � WWW.VICTAMLATAM.COM 3-5 OCTOBER 2023 FOUNDING COMPANIES Industry Events

台湾智能农业周&国际渔业及海鲜展 台湾智能农业周&台湾国际渔业和海鲜展将 于2022年9月29日至10月1日在台北Tainex Hall 1号馆4楼举行,已邀请泰国、越南、新加 坡、马来西亚、印度、印度尼西亚和其他国 家的买家成功参加对接。 随着新日期的到来,他们预计将吸引来自30 多个国家的15000名国内外专业买家前来参观 展览。此外,现场活动、在线展览也将从10 月29日开始举行,为期31天。 提供“一站式”解决方案 “变得智能,共同成长”是台湾智能农业周的 核心理念。该展览将有四个展馆:AGI技术、 农业畜牧、农业+和农业食品,展示智能农 业、可持续和循环畜牧业、环保农业、智能 畜牧业、精准畜牧业、营养与健康、农业、 冷链、食品加工和一体化服务的最新技术。 此外,与“台湾智能农业周”相结合,台湾国 际渔业和海鲜展是台湾唯一的渔业B2B贸易 展。这两个展会旨在提供一站式解决方案, 帮助行业各方进行无缝智能转型。 展会期间,将举行线上线下对接会、数十 场专业论坛、烹饪秀、幸运袋分发等众多活 动。为了延续展会热潮,主办方将于2022年 10月26日至27日在台南举办“动物精准营养论 坛OMO”。 完美的沟通平台 东南亚国家农业、渔业和畜牧业的智能化 转型创造了强劲的市场需求。由于台湾拥有 相同的高温和高湿度,台湾在农业、渔业 和畜牧业方面的技术和产品可以在该地区 使用。 因此,为期30天的“台湾智能农业周”和“台 湾国际渔业与海鲜展”在线展览是展示从遗 传、播种、养殖、种植、营养抗生素养殖到 台湾到该地区冷链运输的完整产业链的完美
东南亚的环境和气候条件相适应。与AMB Tarsus集团的合作必将创造更多买家和卖 家之间的合作,并将台湾相关产业推向全 球,”My Exhibition Co有限公司总经理Irene Liu表示。 虚拟和现场模型 尽管去年有疫情的威胁,主办方还是巧妙地 将虚拟和现场模型应用于展览。大众数字营 销和国际媒体广播提高了国际曝光率,为农 业和水产养殖业提供了各种商机。 尽管这两个活动都面临着普遍的不利情况, 但都吸引了来自36个国家的参展商,参观人 数达到了11000人。该活动也取得了3632万美 元的周交易额。 今年,他们将继续成功的OMO展会模式, 以抵消疫情期间的人员流动限制,并为参展 商争取更多合作机会。 欲了解更多信息,请访问台湾国际渔业与海 鲜展网站:https://aqfeed.info/e/1595 行业盛会 International Aquafeed - 2022年9月 | 59
交流平台。凭借AMB Tarsus集团的业务网络 和专业的海外营销手段,展会将深入东南亚 的农业企业和公司。 “台湾农业、渔业和畜牧业的技术和设备与
Aerators
Air products

Additives
Faivre + 33 3idah 81 84 01 32 www.faivre.fr PROFILE: aqfeed.info/e/1603

Kaeser Kompressoren +49 9561 6400 www.kaeser.com PROFILE: aqfeed.info/e/1035
Dibaq +34 921 574 286 https://dibaqacuicultura.es PROFILE: aqfeed.info/e/1604




DSM +43 2782 8030 www.dsm.com PROFILE: aqfeed.info/e/1605 Evonik +49 618 1596785 www.evonik.com PROFILE: aqfeed.info/e/1606 Jefo +1 450 799 2000 https://jefo.ca PROFILE: aqfeed.info/e/1607

Liptosa +34 902 157711 www.liptosa.com PROFILE: aqfeed.info/e/1608
ORFFA +32 479 50 09 08 https://orffa.com PROFILE: aqfeed.info/e/1278





Phibro +972 4 629 1833 www.phibro-aqua.com PROFILE: aqfeed.info/e/1609
Analysis
SAS Laboratories Phode +33 5 63 77 80 60 www.phode.com PROFILE: aqfeed.info/e/1644
R-Biopharm +44 141 945 2924 www.r-biopharm.com PROFILE: aqfeed.info/e/1645

Romer Labs +43 2272 6153310 www.romerlabs.com PROFILE: aqfeed.info/e/1610
Founded in Washington, MO, in 1982, Romer Labs have over the years become a leading provider of diagnostic solutions for the agricultural, food and feed industry.





Today, Romer Labs offers a broad range of innovative diagnostic solutions covering mycotoxins, food pathogens, food allergens, gluten, GMO, veterinary drug residues, and other food contaminants.
Furthermore, they operate four accredited, fullservice laboratories in Austria, UK, US and Singapore. Using cutting-edge technology in the fields of chromatography and immunological analysis, their labs offer services for the analysis of mycotoxins, food allergens, meat speciation, VDR and GMO.

Romer Labs is at the forefront of diagnostic technology and are constantly expanding their product and service portfolio to meet your continuously evolving demands.


The key objective at Romer Labs is to provide scientifically sound, high-quality products and an exceptional service, in line with their mission –Making the World’s Food Safer®
Amino
618 1596785 www.evonik.com PROFILE: aqfeed.info/e/1606


Bulk storage Silo Construction & Engineering +32 51723128 www.sce.be PROFILE: aqfeed.info/e/1611 Silos Cordoba +34 957 325 165 www.siloscordoba.com aqfeed.info/e/1646 Symaga +34 91 726 43 04 www.symaga.com aqfeed.info/e/1647 TSC Silos +31 543 473979 www.tsc-silos.com PROFILE: aqfeed.info/e/1612 Conveyors Cablevey Conveyors +1 641 673 8451 https://cablevey.com PROFILE: aqfeed.info/e/1613 Vigan Enginnering +32 67 89 50 41 www.vigan.com aqfeed.info/e/1648 Colour sorters Bühler AG +41 71 955 11 11 www.buhlergroup.com PROFILE: aqfeed.info/e/1614 Satake +81 82 420 8560 www.satake-group.com Computer software Inteqnion +31 543 49 44 66 www.inteqnion.com PROFILE: aqfeed.info/e/1277 60 | 2022年9月 - International Aquafeed Welcome to the market place, where you will find suppliers of products and services to the industry - with help from our friends at The International Aquafeed Directory (published by Turret Group) aquafeed.co.uk/web/companies 市场
acids Evonik +49
Coolers
Bühler AG +41 71 955 11 11 www.buhlergroup.com
PROFILE: aqfeed.info/e/1614
Consergra s.l +34 938 772207 www.consergra.com aqfeed.info/e/1650
FAMSUN +86 514 85828888 www.famsungroup.com PROFILE: aqfeed.info/e/1034

FrigorTec GmbH +49 7520 91482-0 www.frigortec.com aqfeed.info/e/1652
IDAH +866 39 902701 www.idah.com PROFILE: aqfeed.info/e/1615
Wenger Manufacturing +1 785-284-2133 www.wenger.com PROFILE: aqfeed.info/e/1616
Yemmak +90 266 733 83 63 www.yemmak.com PROFILE: aqfeed.info/e/1617 Drum
Faivre
Alapala +90 212 465 60 40 www.alapala.com aqfeed.info/e/1653
Tapco Inc +1 314 739 9191 www.tapcoinc.com aqfeed.info/e/1654

IDAH +866 39 902701 www.idah.com PROFILE: aqfeed.info/e/1615


Ottevanger +31 79 593 22 21 www.ottevanger.com PROFILE: aqfeed.info/e/1621
Wenger Manufacturing +1 785-284-2133 www.wenger.com PROFILE: aqfeed.info/e/1616



Yemmak +90 266 733 83 63 www.yemmak.com PROFILE: aqfeed.info/e/1617
Zheng Chang +86 2164184200 www.zhengchang.com PROFILE: aqfeed.info/e/1623

Feed and ingredients
Adisseo +33 1 46 747104 www.adisseo.com PROFILE: aqfeed.info/e/1624
Aller Aqua +45 70 22 19 10 www.aller-aqua.com PROFILE: aqfeed.info/e/961
Alltech +44 1780 764512 www.alltechcoppens.com PROFILE: aqfeed.info/e/1625





Anpario +44 1909 537 380 www.anpario.com PROFILE: aqfeed.info/e/1626
Anpario plc is an independent, international manufacturer and distributor of natural feed additives for aquaculture health, nutrition and biosecurity. Our specialist feed technologies are both innovative and tailored to meet the ever increasing population requirements for healthy food. Anpario’s feed additives are sold in over 80 countries through established sales and distribution networks, which includes a number of wholly owned subsidiaries in key markets around the world. We have over 30 years expertise within agriculture and aquaculture sectors, working with key research institutes and universities across the world in both the development and evaluation our innovative cutting-edge products.
Anpario’s product portfolio of innovative solutions work in harmony with the natural aspects of both the animal’s biology and environment, creating responsible solutions to sustainably optimise health, growth and profitability.





Our mission is to add value throughout the lives of animals so we can help our customers achieve optimum animal performance, with proven return on investment, boosting profitability in today’s modern aquaculture production systems. Our technologies are developed, produced and dispatched directly from our pioneering quality assured manufacturing plant in the UK.
Feed Mill
Biorigin www.biorigin.net

PROFILE: aqfeed.info/e/1627
GePro +49 54415 925252 www.ge-pro.de aqfeed.info/e/1656
Grupo Dibaq +34 921 574 286 www.dibaqacuicultura.es

PROFILE: aqfeed.info/e/1604
Grand Fish Feed +202 20 650018 www.grand-aqua.com PROFILE: aqfeed.info/e/1628 Liptosa +34 902 15 77 11 www.liptoaqua.com
PROFILE: aqfeed.info/e/1608
Phileo (Lesaffre animal care) +33 3 20 81 61 00 www.lesaffre.fr

PROFILE: aqfeed.info/e/1629
Clextral +1 813 854 4434 www.clextral.com
PROFILE: aqfeed.info/e/1620
TekPro +44 1692 403403 www.tekpro.com PROFILE: aqfeed.info/e/1631 Van Aarsen International +31 475 579 444 www.aarsen.com
PROFILE: aqfeed.info/e/1632
Fish
Faivre + 33 3 81 84 01 32 www.faivre.fr
PROFILE: aqfeed.info/e/1603
Fish
Fish

Faivre + 33 3 81 84 01 32 www.faivre.fr
PROFILE: aqfeed.info/e/1603
Faivre + 33 3 81 84 01 32 www.faivre.fr







PROFILE: aqfeed.info/e/1603 Fish
Ace Aquatec + 44 7808 930923 www. aceaquatec.com

PROFILE: aqfeed.info/e/764
Grinders
Almex

Grand Fish Feed +202 20 650018 www.grand-aqua.com







PROFILE: aqfeed.info/e/1628
Hammermills

Dinnissen BV +31 77 467 3555 www.dinnissen.nl


PROFILE: aqfeed.info/e/1633
Yemmak +90 266 733 83 63 www.yemmak.com


PROFILE: aqfeed.info/e/1617 Yemtar +90 266 733 8550 www.yemtar.com aqfeed.info/e/1657

市场
&
driers
filters
buckets
+ 33 3 81 84 01 32 www.faivre.fr PROFILE: aqfeed.info/e/1603 Elevator
& conveyor components
Enzymes
Equipment for sale
Elevator
4B Braime +44 113 246 1800 www.go4b.com aqfeed.info/e/1655
DSM +43 2782 8030 www.dsm.com PROFILE: aqfeed.info/e/1605 Evonik +49 618 1596785 www.evonik.com PROFILE: aqfeed.info/e/1606
Extruders
ExtruTech Inc +1 785 284 2153 www.extru-techinc.com PROFILE: aqfeed.info/e/1618
+31 575 572666 www.almex.nl
aqfeed.info/e/1279 Andritz +45 72 160300 www.andritz.com
aqfeed.info/e/1619 Buhler AG +41 71 955 11 11 www.buhlergroup.com
aqfeed.info/e/1614
+1 813 854 4434
aqfeed.info/e/1620
PROFILE:
PROFILE:
PROFILE:
Clextral
www.clextral.com PROFILE:
counters
Graders
pumps
Stunning
61 | 2022年9月 - International Aquafeed
When maximum volume matters, the Wenger AQUAFLEX XT High Capacity Aquafeed Extruder is the choice, processing up to 12,000 kg/hour. Equipped with either our High Shear Conditioner (HSC) or High Intensity Preconditioner (HIP), the AQUAFLEX XT is ideal for aquatic feeds as small as 0.5 mm. Precise control of finished product density delivers either high capacity floating or sinking feeds.





















































about the industry-changing designs and customized options
PHONE:
| EMAIL: INFO@WENGER.COM | WENGER.COM USA | BELGIUM | TAIWAN | BRASIL | CHINA Maximize capacity, conditioning, and control. WENGER’S AQUAFLEX XT HIGH CAPACITY EXTRUDER THE INNOVATIVE SOLUTION TO CLEANER FISH MANAGEMENT & SEA LICE CONTROL COMPLETE, TAILORED FEED BLOCK DIETS FOR LUMPFISH & WRASSE REDUCED IMPROVED Produced in the UK by www.vitaaquafeeds.uk • SEA LICE POPULATIONS • CATARACT PREVALENCE • AGGRESSION DURING FEEDING • ENERGY CONSUMPTION • STORAGE SPACE & COSTS • MEDICAL TREATMENTS • FISH HEALTH & WELFARE • MORTALITY RATES • STABLE, CONTROLLED GROWTH • LONGEVITY & EFFICACY • PRACTICAL FEEDING METHODS • DAILY OPERATIONAL COSTS 62 | 2022年9月 - International Aquafeed
Know more
of AQUAFLEX Email us at info@wenger.com today.
785.284.2133
Pellet
Hydronix +44 1483 468900 www.hydronix.com PROFILE: aqfeed.info/e/1634

FAWEMA /

+49 22 63 716 0 www.fawema.com PROFILE: aqfeed.info/e/1635

Anderson
www.andersonfeedtech.com aqfeed.info/e/1658



IDAH +866 39 902701 www.idah.com PROFILE: aqfeed.info/e/1615
Clextral +1 813 854 4434 www.clextral.com PROFILE: aqfeed.info/e/1620
IDAH +866 39 902701 www.idah.com PROFILE: aqfeed.info/e/1615 PTN +31 73 54 984 72 www.ptn.nl PROFILE: aqfeed.info/e/1636 Plants Andritz +45 72 160300 www.andritz.com PROFILE: aqfeed.info/e/1619
Buhler AG +41 71 955 11 11 www.buhlergroup.com PROFILE: aqfeed.info/e/1614
Clextral +1 813 854 4434 www.clextral.com PROFILE: aqfeed.info/e/1620 Dinnissen BV +31 77 467 3555 www.dinnissen.nl PROFILE: aqfeed.info/e/1633
FAMSUN +86 514 87848880 www.muyang.com PROFILE: aqfeed.info/e/1034
Ottevanger +31 79 593 22 21 www.ottevanger.com PROFILE: aqfeed.info/e/1621
Yemmak +90 266 733 83 63 www.yemmak.com PROFILE: aqfeed.info/e/1617
Yemtar +90 266 733 8550 www.yemtar.com aqfeed.info/e/1657
Zheng Chang +86 2164184200 www.zhengchang.com

PROFILE: aqfeed.info/e/1623
Probiotics
Ace Aquatec + 44 7808 930923

www. aceaquatec.com
PROFILE: aqfeed.info/e/764
DSM +43 2782 8030 www.dsm.com
PROFILE: aqfeed.info/e/1605
Royal DSM is a global, purpose-led company in Health, Nutrition & Bioscience, applying science to improve the health of people, animals and the planet. DSM’s purpose is to create brighter lives for all. DSM’s products and solutions address some of the world’s biggest challenges while simultaneously creating economic, environmental and societal value for all its stakeholders - customers, employees, shareholders, and society at large. DSM and its associated companies employ approximately 23,000 people around the world and deliver annual net sales of about €10 billion.
DSM use their bright science to deliver positive transformations at scale for as many people as possible today and for generations to come, operating within the constraints of the world’s finite resources. DSM aim to redefine how they live and work in order to create a fairer, more prosperous and more sustainable society.
The DSM Animal Nutrition and Health business group offers customers a true end-to-end portfolio of products, solutions and services for sustainable and profitable animal farming. The company’s three dedicated business lines cover Precision Services, Performance Solutions + Biomin® and Essential Products.




Greater precision in animal farming is key to a more sustainable and profitable future. Their Precision Services use the latest data analytics and diagnostics to improve animal health, lifetime performance, resource use and environmental footprint — while mitigating risks and unlocking more value. Improving the sustainability and profitability of animal farming is secured with Their broad portfolio delivers the level of functional nutrition needed for the industry to meet the challenges of sustainability, animal welfare and feed quality.
Essential nutrition is fundamental to healthy, sustainable animal protein. Their Essential Products provide vital nutrients for an animal’s healthy growth and development — delivered to the customer in the most flexible, tailored way.
As a purpose-led company, for years, DSM has supplied science-based products, services and ground-breaking innovation fundamental to the health, well-being and sustainability of farm animals. With growing demand for sustainable animal protein that is safe, nutritious and affordable, DSM helps the industry transition to a more sustainable future to meet this complex challenge.
#WEMAKEITPOSSIBLE
Pulverisers